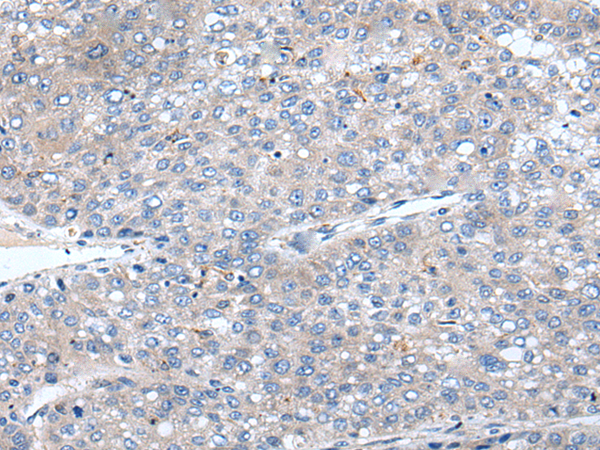

-
分类: 科研抗体货号: P05972别名: PMX1; PRX1; AGOTC; PHOX1; PRX-1应用: IHC反应种属: Human, Mouse, Rat
-
分类: 科研抗体货号: P05974别名: PFTK1; PFTAIRE1应用: WB,IHC反应种属: Human, Mouse
-
分类: 科研抗体货号: P06020别名: UBC13; UbcH13; HEL-S-71; UbcH-ben; UBCHBEN; UBC13应用: WB,IHC反应种属: Human, Mouse, Rat
-
分类: 科研抗体货号: P05970别名: H3/A; H3FA; HIST1H3A应用: WB,IHC反应种属: Human, Mouse
-
分类: 科研抗体货号: P06015别名:应用: WB,IHC反应种属: Human
-
分类: 科研抗体货号: P05964别名: ZNF523; Zfp523; D6S229E应用: WB,IHC反应种属: Human, Mouse, Rat
-
分类: 科研抗体货号: P06011别名: DFNA25; VGLUT3应用: WB,IHC反应种属: Human, Mouse
-
分类: 科研抗体货号: P05962别名: KOX4; zf30; HF.16应用: WB反应种属: Human
-
分类: 科研抗体货号: P06002别名: Atg21; ATG18B; CGI-50; WIPI-2应用: WB,IHC反应种属: Human, Mouse, Rat
-
分类: 科研抗体货号: P06055别名: Boo; Diva; BCL-B; bcl2-L-10应用: IHC反应种属: Human

鄂公网安备42018502007531号
鄂公网安备42018502007531号

